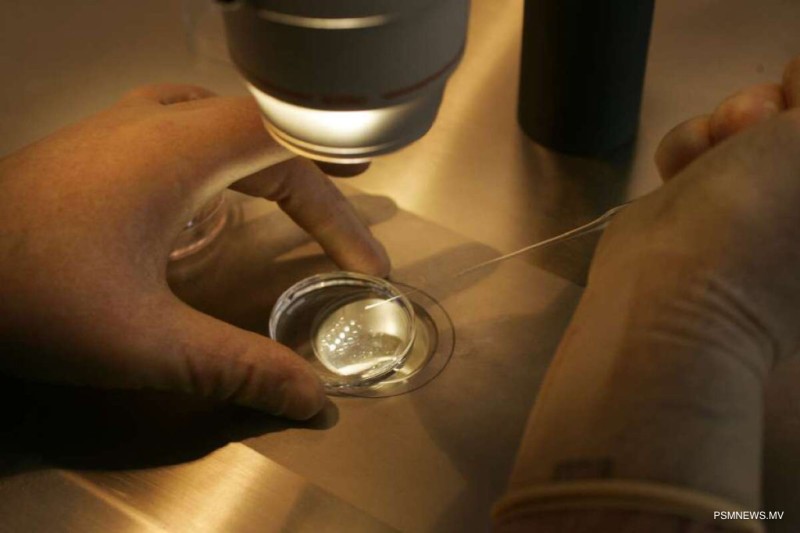
ފަރޓިލިޓީ ކެއަރ ފަންޑުން އައިވީއެފް ހެދުމަށް 37 ދެމަފިރިއަކަށް އެހީ

އައިވީއެފް ހެދުމަށް "ފަރޓިލިޓީ ކެއަރ ފަންޑް"ގެ ދަށުން ހުޅުވާލި ފުރަތަމަ ފުރުޞަތުގައި ޝަރުތު ހަމަވެ، 37 ދެމަފިރިއަކަށް އެހީތެރިކަން ދިނުމަށް ނިންމާފައިވާކަމަށް ނެޝަނަލް ސޯޝަލް ޕްރޮޓެކްޝަން އެޖެންސީ، އެންސްޕާއިން ވިދާޅުވެއްޖެއެވެ.
ސަރުކާރުން ގާއިމްކޮށްފައިވާ "ފަރޓިލިޓީ ކެއަރ ފަންޑް"ގެ އެހީގެ ފުރަތަމަ ބުރުގައި ފަރުވާގެ އެހީއަށް އެދުމަށް ހުޅުވާލީ މިދިޔަ އަހަރުގެ ނޮވެންބަރު މަހުގެ 20 ވަނަ ދުވަހުއެވެ. މި ފުރުޞަތުގައި 50 މީހުންނަށް އެހީތެރިކަން ދިނުމަށް ނިންމާ ފުރުޞަތު ހުޅުވާލިއެވެ.
ފުރުޞަތަށް ހުޅުވާލި 1 މަސް ދުވަހުގެ ތެރޭގައި 135 ދެމަފިރިއަކު ވަނީ މިކަމަށް އެދި ހުށައަޅާފައެވެ. އެންސްޕާއިން މިހާރު ވަނީ މީގެތެރެއިން ޝަރުތު ހަމަވާ ފަރާތްތަކުގެ ލިސްޓު ނެރެފައެވެ. މީގެތެރެއިން އެހީދޭ އެންމެހާ މިންގަނޑުތަކަށް ޝަރުތު ހަމަވެ، 37 ދެމަފިރިއަކަށް އެހީ ދިނުމަށް ވަނީ ނިންމާފައެވެ.
ޝަރުތު ހަމަވާ ފަރާތްތަކުގެ އިތުރުން، މި ލިސްޓުގައި ޝަރުތު ހަމަ ނުވާ ފަރާތްތަކުގެ މަޢުލޫމާތުވެސް، އޭގެ ސަބަބުތަކާއެކު ވަނީ ބަޔާންކޮށްފައެވެ.
ޝަރުތު ހަމަވެ އެހީ ހަމަޖެހިފައިވާ ފަރާތްތަކުން، ފަރުވާ ކުރިއަށްގެންދާނެގޮތުގެ ޓްރީޓްމެންޓް ޕްލޭން ޙިއްސާކުރުމާގުޅޭ މަޢުލޫމާތުތައް މިމަހުގެ 11ގެ ކުރިން އަންގަވާނެކަމަށް އެންސްޕާއިން ވަނީ ވިދާޅުވެފައެވެ.


ނޭޝަނަލް ފަރޓިލިޓީ ސެންޓަރު ނުވަތަ ދަރިމައިވުމުގެ ސިއްޙަތުގެ ޤައުމީ މަރުކަޒު ހުޅުވުން--
އެންސްޕާގެ "ފަރޓިލިޓީ ކެއަރ ފަންޑް" އެކުލަވާލުމުގެ ކުރިން ދެ ބުރެއްގެ މަތިން މިހާތަނަށް އާސަންދައިގެ ދަށުން އައިވީއެފް ފަރުވާއަށް ސަރުކާރުން ވަނީ ހިލޭ ފުރުޞަތު ފަހިކޮށްދީފައެވެ.
އެގޮތުން އާސަންދައިގެ ދަށުން ފަހިކޮށްދިން ދެ ފުރުޞަތުގައި ފުރަތަމަ ބުރުގައި 37 ދެމަފިރިން، އަދި ދެވަނަ ބުރުގައި 63 ދެމަފިރިއަކު ޝަރުތު ހަމަވެ އެހީތެރިކަން ދޭން ނިންމިއެވެ. ޖުމުލަ 368 މީހުން މިކަމަށް އެދި ހުށައަޅާފައިވެއެވެ.
އައިވީއެފަށް ހުށައަޅާއިރު، އެ ފަރުވާއަށް ހޮވޭ މީހުން ކަނޑައަޅަނީ ޞިއްޙީގޮތުން ބަލަންޖެހޭ މިންގަނޑުތަކަކަށް ރިޢާޔަތްކޮށްގެންނެވެ. އައިވީއެފް އާއި އަައިޔޫއައިގެ ފަރުވާއަށް ފަރޓިލިޓީ ފަންޑުން އެހީތެރިވުމުގެ އުސޫލުގައިވާގޮތުން އެހީއަށް އެދެވޭނީ ކައިވެންޏަށް މަދުވެގެން ތިން އަހަރުވެފައިވާ، އަދި ދަރިމައިވުމަށް ހުރަސް އެޅޭ ގުދުރަތީ ސަބަބެއް މެދުވެރިވެފައިވާ މީހުންނަށެވެ. އަދި ދަރިމައިވުމަށް އެހެން ފަރުވާތައްކޮށް ނާކާމިޔާބުވެ، އައިވީއެފް ނުވަތަ އައިޔޫއައި އަކީ އެ ފަރާތަށް އެންމެ އެކަށީގެންވާ ފަރުވާ ކަމަށް ސްޕެޝަލިސްޓުން ލަފާދީފައިވުމަކީ ވެސް ޝަރުތެކެވެ. އަދި މި ފަރުވާއަށް އެކަށީގެންވާ ދުޅަހެޔޮ ޞިއްޙީ ޙާލަތުގައި ތިބި ދެމަފިރިންކަން ކަށަވަރުކުރުމަކީވެސް މުހިންމު ޝަރުތެކެވެ.
ރާއްޖޭގައި ނެޝަނަލް ފަރޓިލިޓީ ސެންޓަރެއް ޤާއިމުކޮށް ދަރިމައިވުމާ ގުޅޭ ފަރުވާގެ ޚިދުމަތް ފުޅާކޮށްފައިވަނީ 15 ނޮވެންބަރު 2024ގައެވެ. ސެންޓަރުގެ ފަރުވާގެ އެހީގައި މިހާތަނަށް ދެ ކުދިން ވަނީ އުފަންވެފައެވެ. އަދި ގިނަ ބަޔަކު އަންނަނީ އެ ސެންޓަރުން ފަރުވާ ހޯދަމުންނެވެ.
އަދި އެކި ފަންޑުތަކުގެ އެހީގައި ސަރުކާރުން ފޯރުކޮށްދެމުންދާ އެހީގައި، ރާއްޖެއިން ބޭރުންވެސް ގިނަ ބަޔަކު އަންނަނީ ފަރުވާ ހޯދަމުންނެވެ.